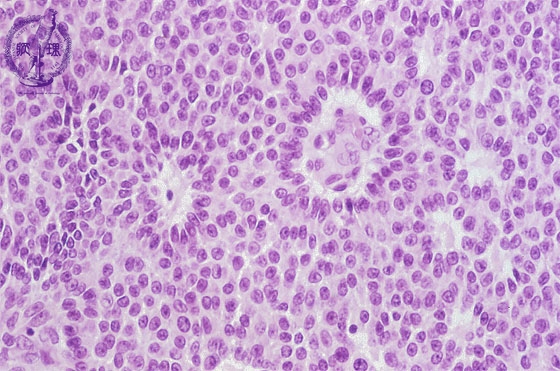

- 15.Female genital organs
- (10)Granular cell tumor
Histology (HE stain, high power): Tumor cells with nuclear groove shows solid growth. Tube-like structure (red dotted line) and numerous Call-Exner bodies (yellow arrow) are identifiable.
Click the image to see the enlarged image.